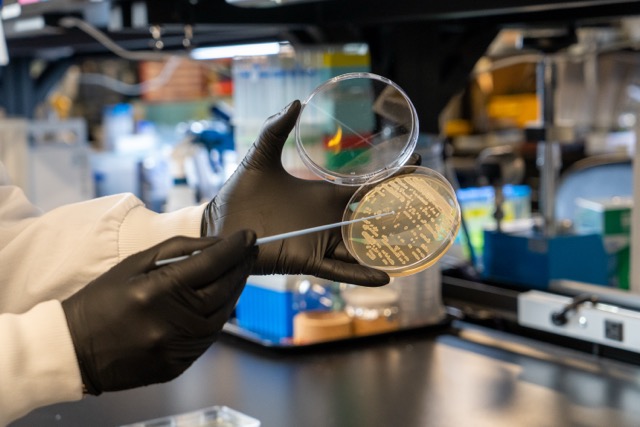
Swabbing a plate in the Kingdom lab

The unmet health needs every pet parent struggles with
Itching. Loose stools. The kind of recurring discomfort that has pet parents cycling through diets and supplements, searching for something that actually works. These aren't rare complaints: they're among the most common reasons owners seek out veterinary care and specialized nutrition.
We set out to do something about that, from the ground up for pets and their unique biology.
Our key insight: indoles, the gut’s own chemical messengers
When a gut microbiome is thriving, it produces a class of compounds called indoles. They're the natural byproducts of a balanced microbial community. And they don't stay in the gut. They’re the gut’s own chemical messengers: indoles circulate throughout the body, and interact with receptors that regulate immune function, skin health, and gut integrity. They’re also supported by a wealth of preclinical and clinical evidence.
The challenge? Pets with compromised gut health produce fewer of them. We developed Superculture® Pet Immune to deliver key indoles and beneficial postbiotic metabolites in a reliable, safe and efficacious manner.
Step 1: Define the target
We started with a clear goal: make a quantifiable impact on the unmet health needs pet parents care most about: in particular, itching and stool quality. From there, we worked backward.
The indole family is broad and varied. Through extensive research, we narrowed in on a set of beneficial indole compounds known to deliver positive health benefits, safe for companion animals, and with the potential to positively impact these specific health needs.
Step 2: Develop high-precision assays
Knowing the target compounds we wanted to deliver wasn’t enough, we needed specific tools to measure them at every stage of development. We developed analytical chemistry methods to detect and quantify these key compounds of interest with high accuracy and precision, enabling us to track beneficial postbiotic compounds across screening, fermentation, and scale-up. These assays became the foundation for every data-driven decision that followed.
Step 3: Screen our proprietary biobank
With our target compounds defined and our measurement tools in place, the next question was: which microbes could produce them to deliver an effective ingredient?
We screened through our strains selected from our proprietary biobank of 25,000 isolates. The results reinforced the importance of selecting the right strain for the job: ultimately, one Pediococcus acidilactici strain emerged as a clear standout.
Step 4: Optimizing fermentation to scale production
Selecting the right microbial strain for Superculture® Pet Immune was only the first part of the mission. Producing it at scale, consistently and efficiently, requires highly optimized and controlled fermentation processes.
To narrow-in on the right fermentation conditions, we built a plate-based fermentation model that let us run hundreds of experiments simultaneously, rather than being limited to a handful of large bioreactor runs. This high-throughput approach dramatically accelerated our ability to test variables.
We systematically explored fermentation conditions to drive consistent production and an efficacious ingredient. Over the course of development, we made more than 20,000 measurements on the key postbiotic compounds like indoles across thousands of experiments, ensuring every optimization decision was grounded in data.
Every promising condition was then validated on benchtop bioreactors to confirm it would hold at scale. We now routinely produce the ingredient through fermentation at large industrial scales.
Step 5: Validate in clinical trials
We’ve validated the efficacy of Superculture® Pet Immune in four independent clinical studies in dogs and cats. These clinical trials demonstrate what no other postbiotic has achieved: significant reduction in occasional itching in dogs, visible coat quality improvement in dogs, improved stool quality in dogs and cats, and increased gut microbiome diversity in dogs (cat gut microbiome data pending analysis). While other postbiotics show limited or no clinical effect on these critical endpoints, Superculture® Pet Immune delivers unprecedented results across all four starting at just 14-28 days.
The result
Superculture® Pet Immune is an ingredient built from the ground up for pets: developed through mechanistic science, rigorous screening, and a fermentation process engineered for maximal production. It's clinically validated for efficacy, meets AAFCO ingredient definitions, is derived from microbial species included on the EU QPS list, and delivers consistent, stable, industry-leading efficacy at commercial scale.
We believe indole compounds, as part of a fermentate, represent an important and underutilized modality for targeting the skin, gut, and immune health needs that matter most to pet parents. That insight drove the development of Superculture® Pet Immune: a precision-fermented ingredient rich in beneficial indole compounds and other bioactive metabolites, designed to deliver these benefits in a form that actually works. To our knowledge, Superculture® Pet Immune is the only postbiotic clinically validated to address occasional itching, skin & coat health, stool quality, and gut microbiome diversity in pets. We’ve completed four clinical trials, and have one more underway on the ingredient. See some of the research for yourself.